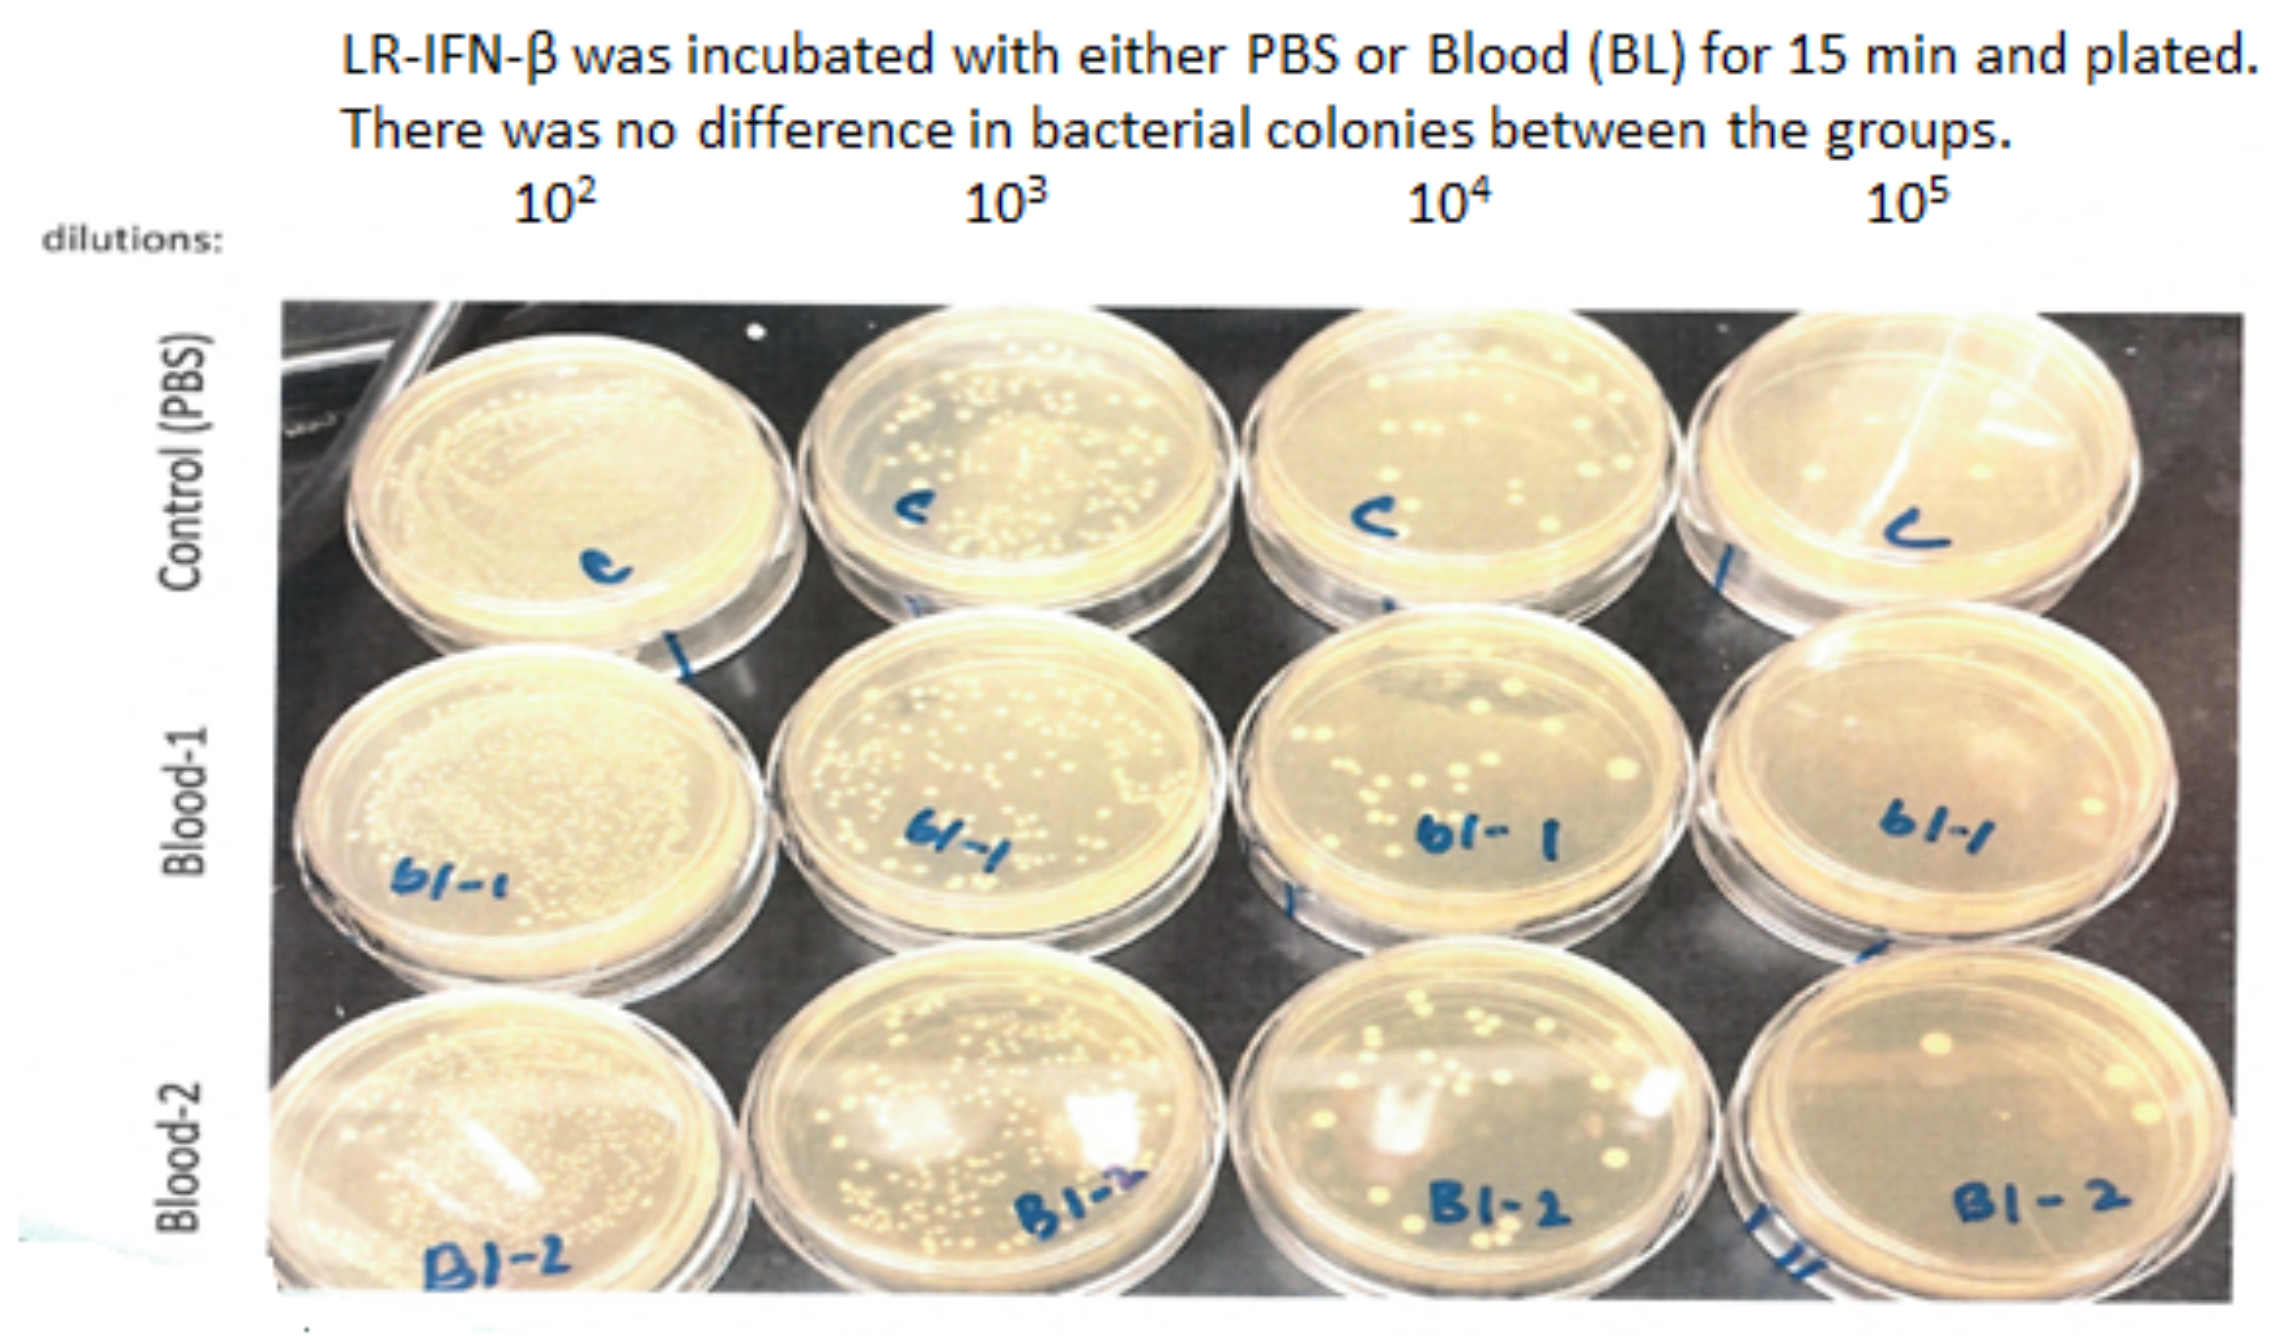
Cancers 15 01670 g013

Release of Interferon-β (IFN-β) from Probiotic Limosilactobacillus reuteri-IFN-β (LR-IFN-β) Mitigates Gastrointestinal Acute Radiation Syndrome (GI-ARS) following Whole Abdominal Irradiation
Abstract
Simple Summary
Abstract
1. Introduction
2. Materials and Methods
2.1. Mouse Model
2.2. Mouse Irradiation
2.3. Construction of LRΔthyA:rpoB(H488R)/pIFNβ-thyA
2.4. Oral Gavage of LR-IFN-β, Control LR, or Intraperitoneal Delivery of IFN-β Protein
2.5. Protein Analysis in Plasma and Small Intestine (Ileum) by Luminex Assay
2.6. Luminex Assay Kits
2.7. Preparation of Reagents and Standards for Immunoassay Bead for Luminex Assays: Quality Controls, Wash Buffer, and Serum Matrix
2.8. Procedures for the 32-Multiplex Luminex Immunoassay
2.9. Measurement of Intestine Levels of Tight Junction Proteins I-CAM and Occludin
2.10. Assay for Intestinal Lgr5+ Stem Cells
2.11. Assay for Intestinal Crypt Regeneration
2.12. Dose-Response Curve of Gavaged LR-IFN-β, Measuring Survival after 13.5 Gy Partial-Body Irradiation
2.13. Measurement of Clearance of Gavaged LR-IFN-β in Male and Female Mice after 13.25 or 13.4 Gy PBI, Respectively
2.14. Physics
2.15. Statistics
3. Results
3.1. LR-IFN-β Gavage Lowers the Levels of Biomarkers of TBI-Induced Intestinal Damage
3.2. LR-IFN-β Gavage Reduces the Biomarkers of Intestinal Irradiation Damage
3.3. LR-IFN-β Ameliorates the Irradiation-Induced Decrease in Lgr5+ Green Fluorescent Protein (Lgr5+GFP+) in the Intestine of Mice following TBI and Stimulates the Biomarkers of Crypt Regeneration
3.4. LR-IFN-β Improves Survival of Mice after TBI or WAI
3.5. Optimal Bacterial Dose Required for Gavage of LR-IFN-β
3.6. LR-IFN-β Delivered by Gavage Is Rapidly Cleared from the Intestine, and Bacterial Growth Is Not Detected in Plasma
4. Discussion
5. Conclusions
Supplementary Materials
Author Contributions
Funding
Institutional Review Board Statement
Informed Consent Statement
Data Availability Statement
Conflicts of Interest
References
- Haie, C.; Pejovic-Lenfant, M.H.; George, M.; Michel, G.; Gerbaulet, A.; Prade, M.; Chassagne, D. Whole abdominal irradiation following chemotherapy in patients with minimal residual disease after second look surgery in ovarian carcinoma. Int. J. Radiat. Oncol. Biol. Phys. 1989, 17, 15–19. [Google Scholar] [CrossRef] [PubMed]
- Bolis, G.; Zanaboni, F.; Vanoli, P.; Russo, A.; Franchi, M.; Scarfone, G.; Pecorelli, S. The impact of whole-abdomen radiotherapy on survival in advanced ovarian cancer patients with minimal residual disease after chemotherapy. Gynecol. Oncol 1990, 39, 150–154. [Google Scholar] [CrossRef] [PubMed]
- Pickel, H.; Lahousen, M.; Petru, E.; Stettner, H.; Hackl, A.; Kapp, K.; Winter, R. Consolidation radiotherapy after carboplatin-based chemotherapy in radically operated advanced ovarian cancer. Gynecol. Oncol. 1999, 72, 215–219. [Google Scholar] [CrossRef] [PubMed]
- Dembo, A.J. Epithelial ovarian cancer: The role of radiotherapy. Int. J. Radiat. Oncol. Biol. Phys. 1992, 22, 835–845. [Google Scholar] [CrossRef] [PubMed]
- May, L.F.; Belinson, J.L.; Roland, T.A. Palliative benefit of radiation therapy in advanced ovarian cancer. Gynecol. Oncol. 1990, 37, 408–411. [Google Scholar] [CrossRef]
- Faul, C.; Gerszten, K.; Edwards, R.; Land, S.; D’Angelo, G.; Kelley, J., III; Price, F. A phase I/II study of hypofractionated whole abdominal radiation therapy in patients with chemoresistant ovarian carcinoma: Karnofsky score determines treatment outcome. Int. J. Radiat. Oncol. Biol. Phys. 2000, 47, 749–754. [Google Scholar] [CrossRef]
- Kunos, C.; Sill, M.; Buekers, T.; Walker, J.; Schilder, J.; Yamada, S.; Waggoner, S.E.; Mohiuddin, M.; Fracasso, P.M. Low-dose abdominal radiation as a docetaxel chemosensitizer for recurrent epithelial ovarian cancer: A phase 1 study of the Gynecologic Oncology Group. Gynecol. Oncol. 2011, 120, 224–228. [Google Scholar] [CrossRef] [PubMed]
- Ngoi, N.Y.L.; Heong, V.; Tang, J.I.; Choo, B.A.; Kumarakulasinghe, N.B.; Lim, D.; Low, M.; Lim, S.E.; Lim, Y.W.; Leong, Y.H.; et al. Phase I study of low-dose fractionated whole abdominal radiation therapy in combination with weekly paclitaxel for platinum-resistant ovarian cancer (GCGS-01). Int. J. Radiat. Oncol. Biol. Phys. 2021, 109, 701–711. [Google Scholar] [CrossRef] [PubMed]
- Arians, N.; Kieser, M.; Benner, L.; Rochet, N.; Schroder, L.; Katayama, S.; Herfarth, K.; Schubert, K.; Schneeweiss, A.; Sohn, C.; et al. Adjuvant intensity modulated whole-abdominal radiation therapy for high-risk patients with ovarian cancer FIGO stage III: Final results of a prospective phase 2 study. Radiat. Oncol. 2019, 14, 179. [Google Scholar] [CrossRef]
- Dembo, A.J. The role of radiotherapy in ovarian cancer. Bull. Cancer 1982, 69, 275–283. [Google Scholar]
- Mun, S.; Jang, S.-H.; Ryu, A. Early-stage ovarian carcinoma with symptoms mimicking tuberculous peritonitis in a postmenopausal woman. Medicine 2018, 97, e12669. [Google Scholar] [CrossRef]
- Jayson, G.C.; Kohn, E.C.; Kitchener, H.C.; Ledermann, J.A. Ovarian cancer. Lancet 2014, 384, 1376–1388. [Google Scholar] [CrossRef]
- Perren, T.J.; Swart, A.M.; Pfisterer, J.; Ledermann, J.A.; Pujade-Lauraine, E.; Kristensen, G.; Carey, M.S.; Beale, P.; Cervantes, A.; Kurzeder, C.; et al. A phase 3 trial of bevacizumab in ovarian cancer. N. Engl. J. Med. 2011, 365, 2484–2496. [Google Scholar] [CrossRef] [PubMed]
- Burger, R.A.; Brady, M.R.; Bookman, M.A.; Fleming, F.G.; Monk, B.J.; Huang, H.; Mannel, R.S.; Homesley, H.D.; Fowler, J.; Greer, B.E.; et al. Incorporation of bevacizumab in the primary treatment of ovarian cancer. N. Engl. J. Med. 2011, 365, 2473–2483. [Google Scholar] [CrossRef] [PubMed]
- Smith, J.P.; Rutledge, F.N.; Delclos, L. Postoperative treatment of early cancer of the ovary: A random trial between postoperative irradiation and chemotherapy. Natl. Cancer. Inst. Monogr. 1975, 42, 149–153. [Google Scholar] [PubMed]
- Carey, M.S.; Dembo, A.J.; Simm, J.E.; Fyles, A.W.; Treger, T.; Bush, R.S. Testing the validity of a prognostic classification in patients with surgically optimal ovarian carcinoma: A 15-year review. Int. J. Gynecol. Cancer 1993, 3, 24–35. [Google Scholar] [CrossRef]
- Grabosch, S.; Zeng, F.; Zhang, L.; Strange, M.; Brozick, J.; Edwards, R.P.; Vlad, A. PD-L1 biology in response to chemotherapy in vitro and in vivo in ovarian cancer. J. Immunother. Cancer 2015, 3, P302. [Google Scholar] [CrossRef]
- Hamade, D.F.; Espinal, A.; Yu, J.; Leibowitz, B.J.; Fisher, R.; Hou, W.; Shields, D.; van Pijkeren, J.-P.; Mukherjee, A.; Epperly, M.W.; et al. Lactobacillus reuteri Releasing IL-22 (LR-IL-22) Facilitates Intestinal Radioprotection for Whole-Abdomen Irradiation (WAI) of Ovarian Cancer. Radiat. Res. 2022, 198, 89–105. [Google Scholar] [CrossRef] [PubMed]
- Espinal, A.; Epperly, M.W.; Mukherjee, A.; Fisher, R.; Shields, D.; Wang, H.; Huq, M.S.; Hamade, D.F.; Vlad, A.; Coffman, L.; et al. Intestinal radiation protection and mitigation by second-generation probiotic Lactobacillus-reuteri engineered to deliver Interleukin-22. Int. J. Mol. Sci. 2022, 23, 5616. [Google Scholar] [CrossRef] [PubMed]
- Zhang, X.; Fisher, R.; Hou, W.; Shields, D.; Epperly, M.W.; Wang, H.; Yu, J.; van Pijkeren, J.P.; Watkins, S.; Wipf, P.; et al. Second generation probiotics producing IL-22 increase survival of mice after total body irradiation. In Vivo 2020, 34, 39–50. [Google Scholar] [CrossRef] [PubMed]
- Leibowitz, B.J.; Zhao, G.; Wei, L.; Ruan, H.; Epperly, M.; Chen, L.; Lu, X.; Greenberger, J.S.; Zhang, L.; Yu, J. Interferon β drives intestinal regeneration after radiation. Sci. Adv. 2021, 7, eabl5253. [Google Scholar] [CrossRef]
- Haag, S.M.; Gulen, M.F.; Reymond, L.; Gibelin, A.; Abrami, L.; Decout, A.; Heymann, M.; van der Goot, F.G.; Turcatti, G.; Behrendt, R.; et al. Targeting STING with covalent small-molecule inhibitors. Nature 2018, 559, 269–273. [Google Scholar] [CrossRef]
- Steinman, J.; Epperly, M.; Hou, W.; Willis, J.; Wang, H.; Fisher, R.; Liu, B.; Bahar, I.; McCaw, T.; Kagan, V.; et al. Improved total-body irradiation survival by delivery of two radiation mitigators that target distinct cell death pathways. Radiat. Res. 2018, 189, 68–83. [Google Scholar] [CrossRef]
- Thermozier, S.; Hou, W.; Zhang, X.; Shields, D.; Fisher, R.; Bayir, H.; Kagan, V.; Yu, J.; Liu, B.; Bahar, I.; et al. Anti-ferroptosis drug, Baicalein, enhances total body irradiation mitigation by two other drugs that target apoptosis and necroptosis. Radiat. Res. 2020, 195, 435–450. [Google Scholar] [CrossRef] [PubMed]
- Van Pijkeren, J.-P.; Britton, R.A. High efficiency recombineering in lactic acid bacteria. Nucleic Acids. Res. 2012, 40, e76. [Google Scholar] [CrossRef]
- Alexander, L.M.; Oh, J.-H.; Stapleton, D.S.; Schueler, K.L.; Keller, M.P.; Attie, A.D.; van Pijkeren, J.-P. Exploiting prophage-mediated lysis for biotherapeutic release by Lactobacillus reuteri. Appl. Environ. Microbiol. 2019, 85, e02335-18. [Google Scholar] [CrossRef] [PubMed]
- Wei, L.; Leibowitz, B.J.; Wang, X.; Epperly, M.; Greenberger, J.; Zhang, L.; Yu, J. Inhibition of CDK4/6 protects against radiation-induced intestinal injury in mice. J. Clin. Invest. 2016, 126, 4076–4086. [Google Scholar] [CrossRef] [PubMed]
- Wei, L.; Leibowitz, B.J.; Epperly, M.; Bi, C.; Li, A.; Steinman, J.; Wipf, P.; Li, S.; Zhang, L.; Greenberger, J.; et al. The GS-nitroxide JP4-039 improves intestinal barrier and stem cell recovery in irradiated mice. Sci. Rep. 2018, 8, 2072. [Google Scholar] [CrossRef]
- Hendrikx, T.; Duan, Y.; Wang, Y.; Oh, J.-H.; Alexander, L.M.; Huang, W.; Starkel, P.; Ho, S.B.; Gao, B.; Fiehn, O.; et al. Bacteria engineered to produce IL-22 in intestine induce expression of REG3G to reduce ethanol-induced liver disease in mice. Gut 2019, 68, 1504–1515. [Google Scholar] [CrossRef] [PubMed]
- Qiu, W.; Carson-Walter, E.B.; Liu, H.; Epperly, M.; Greenberger, J.S.; Zambetti, G.P.; Zhang, L.; Yu, J. PUMA regulates intestinal progenitor cell radiosensitivity and gastrointestinal syndrome. Cell Stem. Cell 2008, 2, 576–583. [Google Scholar] [CrossRef]
- Leibowitz, B.J.; Yang, L.; Wei, L.; Buchanan, M.E.; Rachid, M.; Parise, R.A.; Beumer, J.H.; Eiseman, J.L.; Schoen, R.E.; Zhang, L.; et al. Targeting p53-dependent stem cell loss for intestinal chemoprotection. Sci. Transl. Med. 2018, 10, eaam7610. [Google Scholar] [CrossRef]
- Decout, A.; Katz, J.D.; Venkatraman, S.; Ablasser, A. The cGAS–STING pathway as a therapeutic target in inflammatory diseases. Nat. Rev. Immunol. 2021, 21, 548–569. [Google Scholar] [CrossRef]
- Ligumsky, M.; Kuperstein, V.; Nechushtan, H.; Zhang, Z.; Razin, E. Analysis of cytokine profile in human colonic mucosal Fc epsilonRI-positive cells by single cell PCR: Inhibition of IL-3 expression in steroid-treated IBD patients. FEBS Lett. 1997, 413, 436–440. [Google Scholar] [CrossRef]
- Fujino, S.; Andoh, A.; Bamba, S.; Ogawa, A.; Hata, K.; Araki, Y.; Bamba, T.; Fujiyama, Y. Increased expression of interleukin 17 in inflammatory bowel disease. Gut 2003, 52, 65–70. [Google Scholar] [CrossRef]
- Langer, V.; Vivi, E.; Regensburger, D.; Winkler, T.H.; Waldner, M.J.; Rath, T.; Schmid, B.; Skottke, L.; Lee, S.; Jeon, N.L.; et al. IFN-γ drives inflammatory bowel disease pathogenesis through VE-cadherin-directed vascular barrier disruption. J. Clin. Invest. 2019, 129, 4691–4707. [Google Scholar] [CrossRef] [PubMed]
- Alme, A.K.; Karir, B.S.; Faltas, B.M.; Drake, C.G. Blocking immune checkpoints in prostate, kidney, and urothelial cancer: An overview. Urol. Oncol. 2016, 34, 171–181. [Google Scholar] [CrossRef] [PubMed]
- Sato, E.; Olson, S.H.; Ahn, J.; Bundy, B.; Nishikawa, H.; Qian, F.; Jungbluth, A.A.; Frosina, D.; Gnjatic, S.; Ambrosone, C.; et al. Intraepithelial CD81 tumor-infiltrating lymphocytes and a high CD81/regulatory T cell ratio are associated with favorable prognosis in ovarian cancer. Proc. Natl. Acad. Sci. USA 2005, 102, 18538–18543. [Google Scholar] [CrossRef]
- Hwang, W.T.; Adams, S.F.; Tahirovic, E.; Hagemann, I.S.; Coukos, G. Prognostic significance of tumor-infiltrating T cells in ovarian cancer: A meta-analysis. Gynecol. Oncol. 2012, 124, 192–198. [Google Scholar] [CrossRef] [PubMed]
- Gonzalez-Martin, A.; Sanchez-Lorenzo, L. Immunotherapy with checkpoint inhibitors in patients with ovarian cancer: Still promising? Cancer 2019, 125, 4616–4622. [Google Scholar] [CrossRef] [PubMed]
- Zamarin, D.; Burger, R.A.; Sill, M.W.; Powell, D.J., Jr.; Lankes, H.A.; Feldman, M.A.; Zivanovic, O.; Gunderson, C.; Ko, E.; Mathews, C.; et al. Randomized Phase II trial of Nivolumab versus Nivolumab and Ipilimumab for recurrent or persistent Ovarian cancer: An NRG Oncology Study. J. Clin. Oncol. 2020, 38, 1814–1823. [Google Scholar] [CrossRef]
- Hamanishi, J.; Mandai, M.; Iwasaki, M.; Okazaki, T.; Tanaka, Y.; Yamaguchi, K.; Higuchi, R.; Yagi, H.; Takakura, K.; Minato, N.; et al. Programmed cell death 1 ligand 1 and tumor infiltrating CD8+ T lymphocytes are prognostic factors of human ovarian cancer. Proc. Natl. Acad. Sci. USA 2007, 104, 3360–3365. [Google Scholar] [CrossRef]
- Liu, J.; Gordon, M.; Veneris, J.; Braiteh, F.; Balmanoukian, A.; Eder, J.P.; Oaknin, A.; Hamilton, E.; Wang, Y.; Sarkar, I.; et al. Safety, clinical activity, and biomarker assessments of atezolizumab from a Phase I study in advanced/recurrent ovarian and uterine cancers. Gynecol. Oncol. 2019, 154, 314–322. [Google Scholar] [CrossRef]
- Disis, M.L.; Taylor, M.H.; Kelly, K.; Beck, J.T.; Gordon, M.; Moore, K.M.; Patel, M.R.; Chaves, J.; Park, H.; Mita, A.C.; et al. Efficacy and safety of avelumab for patients with recurrent or refractory ovarian cancer: Phase 1b results from the JAVELIN solid tumor trial. JAMA Oncol. 2019, 5, 393–401. [Google Scholar] [CrossRef]
- Drew, Y.; De Jonge, M.; Hong, S.H.; Park, Y.H.; Wolfer, A.; Brown, J.; Ferguson, M.; Gore, M.E.; Alvarez, R.H.; Gresty, C.; et al. An open-label, phase II basket study of olaparib and durvalumab (MEDIOLA): Results in germline BRCA-mutated (gBRCAm) platinum-sensitive relapsed (PSR) ovarian cancer (OC). Gynecol. Oncol. 2018, 149, 246–247. [Google Scholar] [CrossRef]
- Lee, J.M.; Cimino, M.A.; Peer, C.J.; Zimmer, A.; Lipkowitz, S.; Annunziata, C.M.; Cao, L.; Harrell, M.I.; Swisher, E.M.; Houston, N.; et al. Safety and clinical activity of the programmed death-ligand 1 inhibitor Durvalumab in combination with poly (ADP-Ribose) polymerase inhibitor Olaparib or vascular endothelial growth factor receptor 1–3 inhibitor Cediranib in women’s cancers: A dose-escalation, Phase I Study. J. Clin. Oncol. 2017, 35, 2193–2202. [Google Scholar] [CrossRef] [PubMed]
- Herrera, F.G.; Ronet, C.; Ochoa de Olza, M.; Barras, D.; Crespo, I.; Andreatta, M.; Corria-Osorio, J.; Spill, A.; Benedetti, F.; Genolet, R.; et al. Low dose radiotherapy reverses tumor immune desertification and resistance to immunotherapy. Cancer Discov. 2021, 12, 108–133. [Google Scholar] [CrossRef] [PubMed]
- Ansaldo, E.; Belkaid, Y. How microbiota improve immunotherapy. Science 2021, 373, 966–967. [Google Scholar] [CrossRef]
- Hu, Y.; Paris, S.; Barsoumian, H.; Abana, C.O.; He, K.; Wasley, M.; Younes, A.I.; Masrorpour, F.; Chen, D.; Yang, L.; et al. Radiation therapy enhanced by NBTXR3 nanoparticles overcomes anti-PD1 resistance and evokes abscopal effects. Int. J. Radiat. Oncol. Biol. Phys. 2021, 111, 647–657. [Google Scholar] [CrossRef]
- Herrera, F.G.; Irving, M.; Kandalaft, L.E.; Coukos, G. Rational combinations of immunotherapy with radiotherapy in ovarian cancer. Lancet Oncol. 2019, 20, 417–433. [Google Scholar] [CrossRef]

| Protein | Function |
|---|---|
| TGF-β | Inflammation, pro-fibrotic controls proliferation, and cellular differentiation |
| TNF-α | Inflammatory cytokine-stimulates necroptosis |
| IL-1α | Pro-inflammatory |
| IL-1β | Pro-inflammatory |
| IL-2 | Natural response to microbial infection: regulates activities of white blood cells |
| IL-3 | Stimulates hematopoietic stem cells to become myeloid progenitor cells |
| IL-4 | Stimulation of activated B-cell and T-cell proliferation, and stimulates B cells into plasma cells |
| IL-5 | Stimulates B cell growth and increases immunoglobulin secretion |
| IL-6 | Pro-inflammatory |
| IL-7 | Stimulates hematopoietic stem cell differentiation into lymphoid progenitor cells |
| IL-9 | Stimulates cell proliferation and prevents apoptosis |
| IL-10 | Anti-inflammatory |
| IL-12 (p40) | Stimulates growth and function of T cells and stimulates IFN-γ and TNF-α |
| IL-12 (p70) | Stimulates growth and function of T cells and stimulates IFN-γ and TNF-α |
| IL-13 | Mediator of allergic inflammation and induces MMPs |
| IL-15 | Induces proliferation of natural killer cells |
| IL-17 | Recruits monocytes and neutrophils to sites of inflammation |
| IP-10 | Chemoattractant for monocytes/macrophages, T cells, NK cells, and dendritic cells |
| KC | Attracts neutrophils |
| LIF | Stem cell differentiation |
| LIX | Cell migration and activation of neutrophils |
| MCP-1 | Recruits monocytes, T cells, and dendritic cells to sites of inflammation |
| M-CSF | Induces hematopoietic stem cells to differentiate into macrophages |
| MIG | T-cell chemoattractant |
| MIP-1α | Recruitment and activation of granulocytes |
| MIP-1β | Chemoattractant for NK cells, monocytes, and other immune cells |
| MIP-2 | Recruits neutrophils and lymphocytes in the intestine |
| RANTES | Recruits leukocytes into inflammatory sites |
| VEGF | Stimulates vasculogenesis and angiogenesis |
| Eotaxin | Recruits eosinophils |
| GM-CSF | Stimulates hematopoietic stem cells to produce granulocytes (neutrophils, eosinophils, and basophils), and monocytes |
| G-CSF | Stimulates hematopoietic stem cells to produce granulocytes |
| IFN-γ | Activator of macrophages and inducer of class II major histocompatibility complex (MHC) molecule expression |
Disclaimer/Publisher’s Note: The statements, opinions and data contained in all publications are solely those of the individual author(s) and contributor(s) and not of MDPI and/or the editor(s). MDPI and/or the editor(s) disclaim responsibility for any injury to people or property resulting from any ideas, methods, instructions or products referred to in the content. |
© 2023 by the authors. Licensee MDPI, Basel, Switzerland. This article is an open access article distributed under the terms and conditions of the Creative Commons Attribution (CC BY) license (https://creativecommons.org/licenses/by/4.0/).
Share and Cite
Hamade, D.F.; Epperly, M.W.; Fisher, R.; Hou, W.; Shields, D.; van Pijkeren, J.-P.; Mukherjee, A.; Yu, J.; Leibowitz, B.J.; Vlad, A.M.; et al. Release of Interferon-β (IFN-β) from Probiotic Limosilactobacillus reuteri-IFN-β (LR-IFN-β) Mitigates Gastrointestinal Acute Radiation Syndrome (GI-ARS) following Whole Abdominal Irradiation. Cancers 2023, 15, 1670. https://doi.org/10.3390/cancers15061670
Hamade DF, Epperly MW, Fisher R, Hou W, Shields D, van Pijkeren J-P, Mukherjee A, Yu J, Leibowitz BJ, Vlad AM, et al. Release of Interferon-β (IFN-β) from Probiotic Limosilactobacillus reuteri-IFN-β (LR-IFN-β) Mitigates Gastrointestinal Acute Radiation Syndrome (GI-ARS) following Whole Abdominal Irradiation. Cancers. 2023; 15(6):1670. https://doi.org/10.3390/cancers15061670
Chicago/Turabian StyleHamade, Diala F., Michael W. Epperly, Renee Fisher, Wen Hou, Donna Shields, Jan-Peter van Pijkeren, Amitava Mukherjee, Jian Yu, Brian J. Leibowitz, Anda M. Vlad, and et al. 2023. "Release of Interferon-β (IFN-β) from Probiotic Limosilactobacillus reuteri-IFN-β (LR-IFN-β) Mitigates Gastrointestinal Acute Radiation Syndrome (GI-ARS) following Whole Abdominal Irradiation" Cancers 15, no. 6: 1670. https://doi.org/10.3390/cancers15061670
APA StyleHamade, D. F., Epperly, M. W., Fisher, R., Hou, W., Shields, D., van Pijkeren, J.-P., Mukherjee, A., Yu, J., Leibowitz, B. J., Vlad, A. M., Coffman, L., Wang, H., Huq, M. S., Huang, Z., Rogers, C. J., & Greenberger, J. S. (2023). Release of Interferon-β (IFN-β) from Probiotic Limosilactobacillus reuteri-IFN-β (LR-IFN-β) Mitigates Gastrointestinal Acute Radiation Syndrome (GI-ARS) following Whole Abdominal Irradiation. Cancers, 15(6), 1670. https://doi.org/10.3390/cancers15061670

